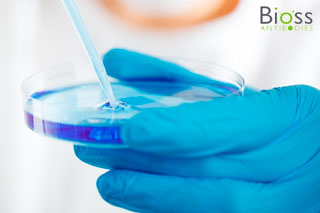

Tech Tips
Featured Tips
A Guide to Hepatocyte Test System Selection for ADME Studies
O-Y-O link: Antibody Conjugation User Manual:
Amino Acid Structures: Reference Table
Lipid Nanoparticle Formulation: Basic Concepts & Preparation Procedures
Choosing & Using Chemical Probes
Application Note: Selective In Vitro Culture of Primary Cancer Cells from Human Tumor Samples